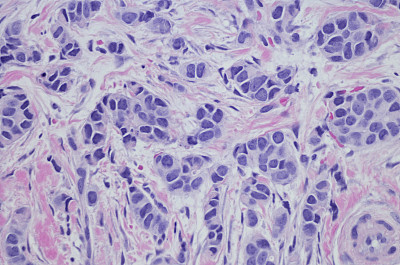

组织学

请先登录后再下载
58明星,组织学,大倍数放大,人体细胞,癌细胞,苏木素伊红染色,显微图片,人体肌肉结缔组织,光显微图,微生物学,细胞,免疫系统,淋巴结,显微镜载玻片,生理学,癌症,β-细胞,淋巴系统,显微镜,放大效果,生物学,肿瘤,科学,自然图案,血液,人体结构,人体内脏器官,身体检查,背景,研究,淋巴瘤,生病,彩色图片,水平画幅,健康保健,生长,摄影,式样,教育,美国,图像